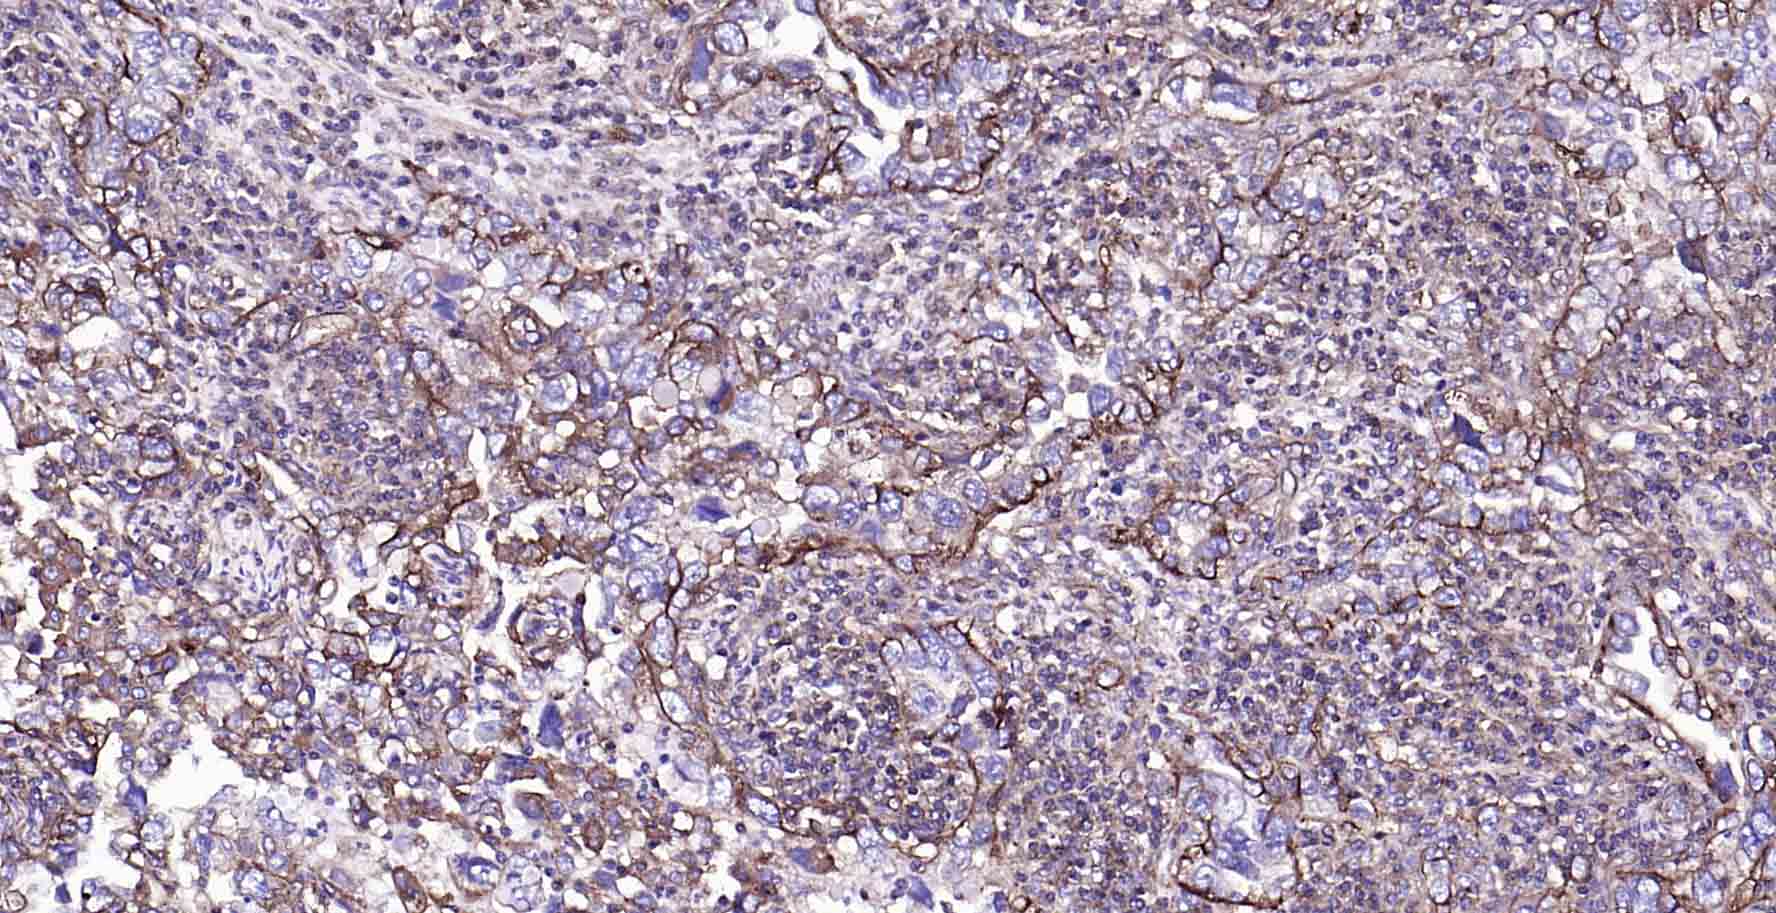
钠钾ATP酶蛋白a1单克隆抗体-bsm-34014M
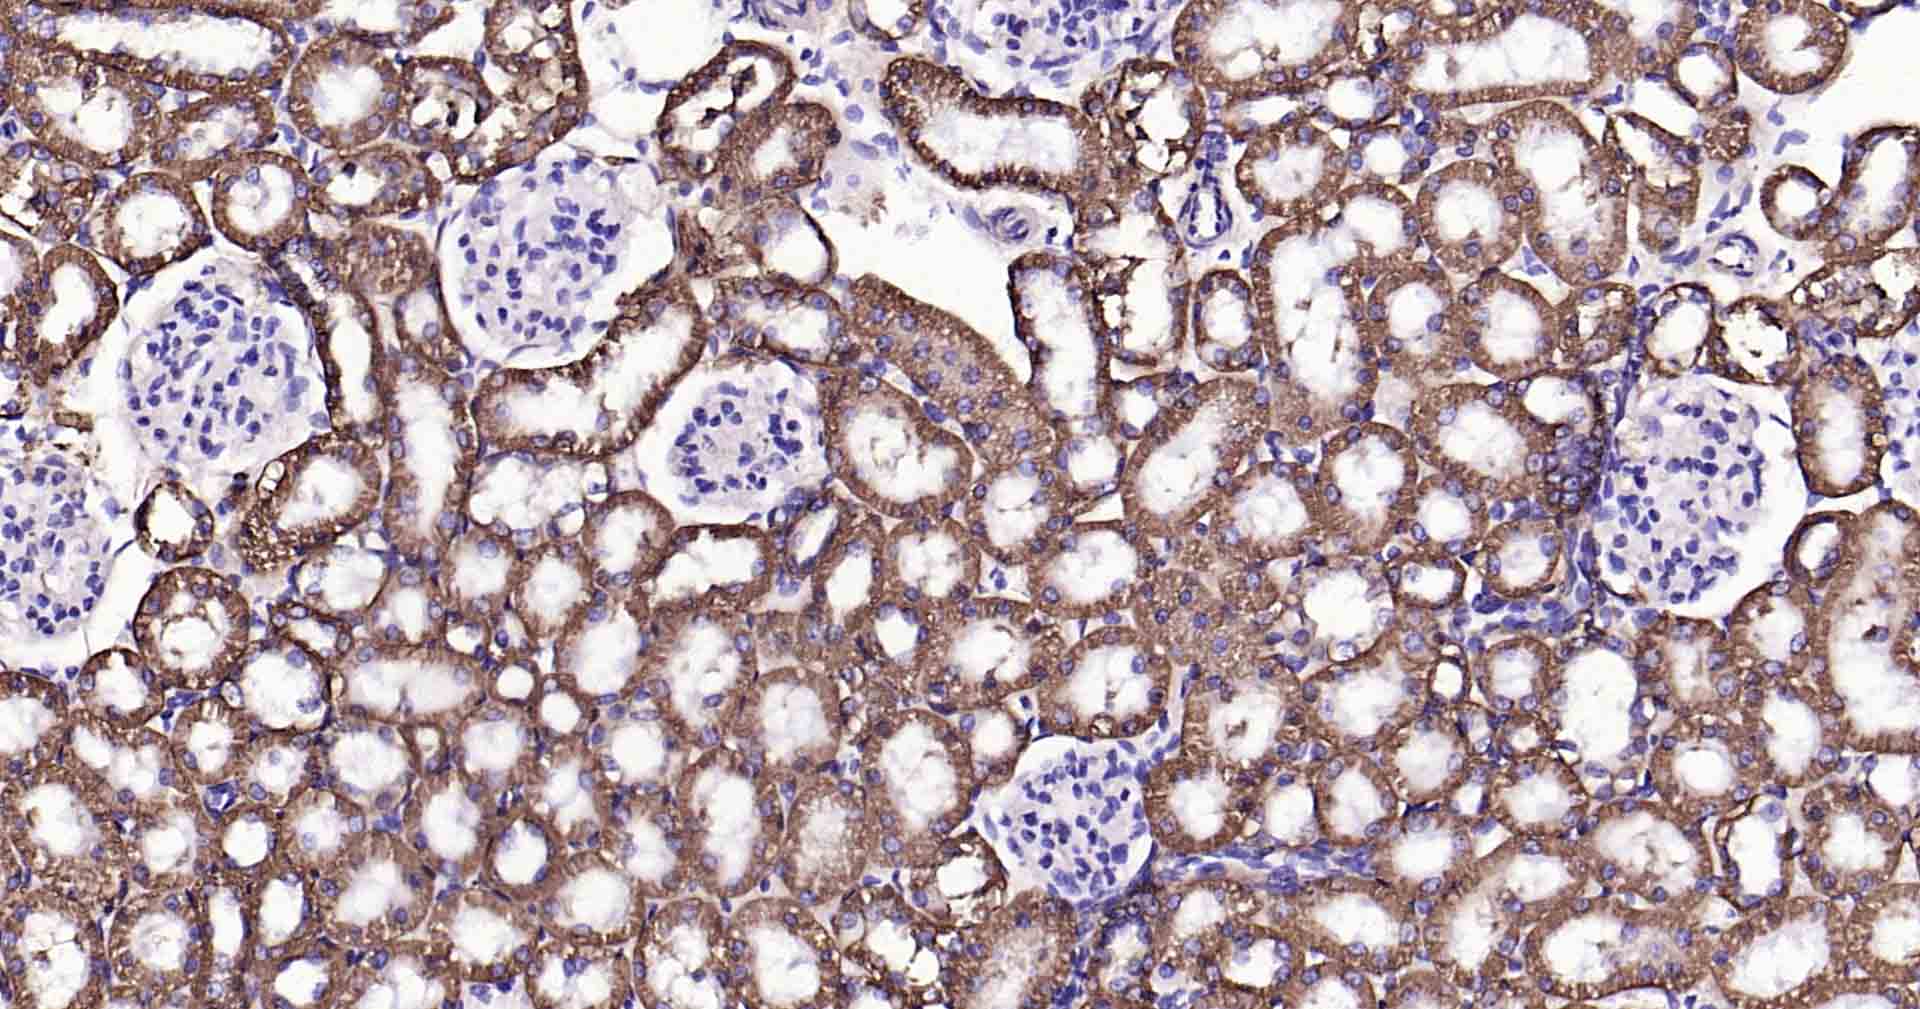
钠钾ATP酶蛋白a1单克隆抗体-bsm-34014M
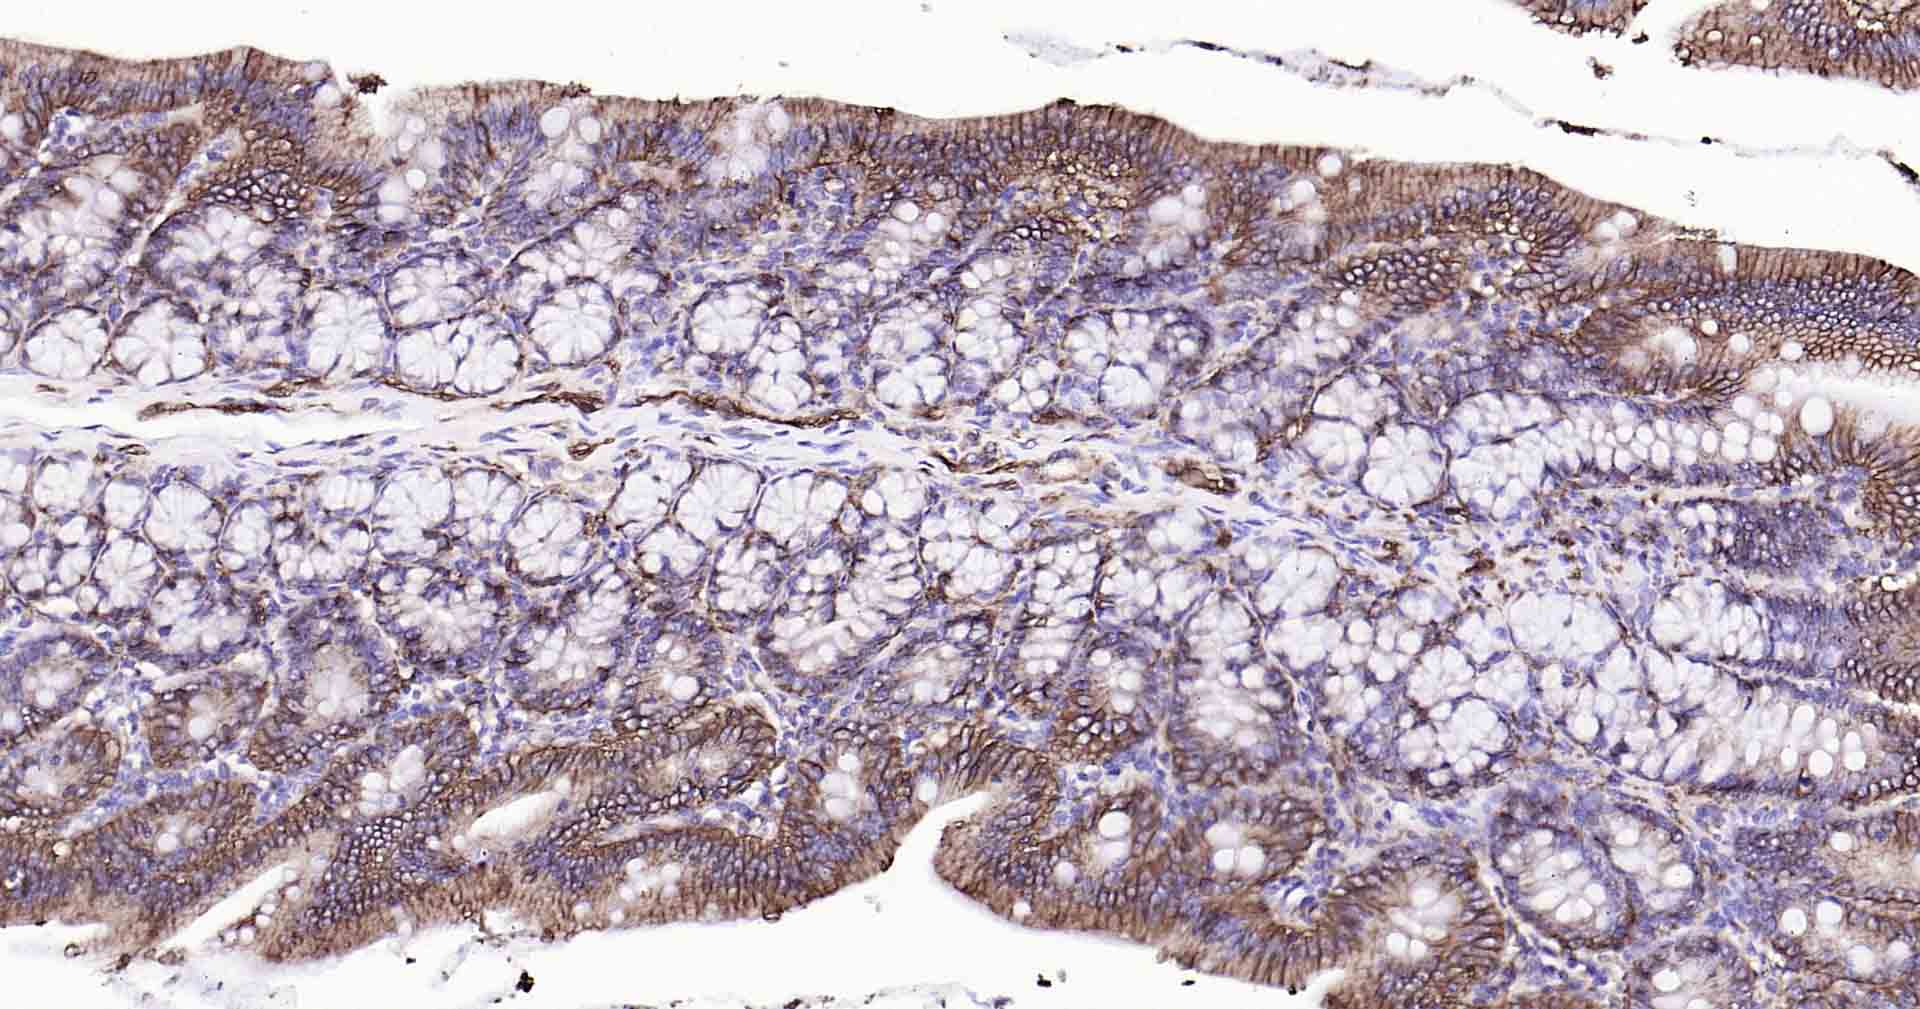
钠钾ATP酶蛋白a1单克隆抗体-bsm-34014M
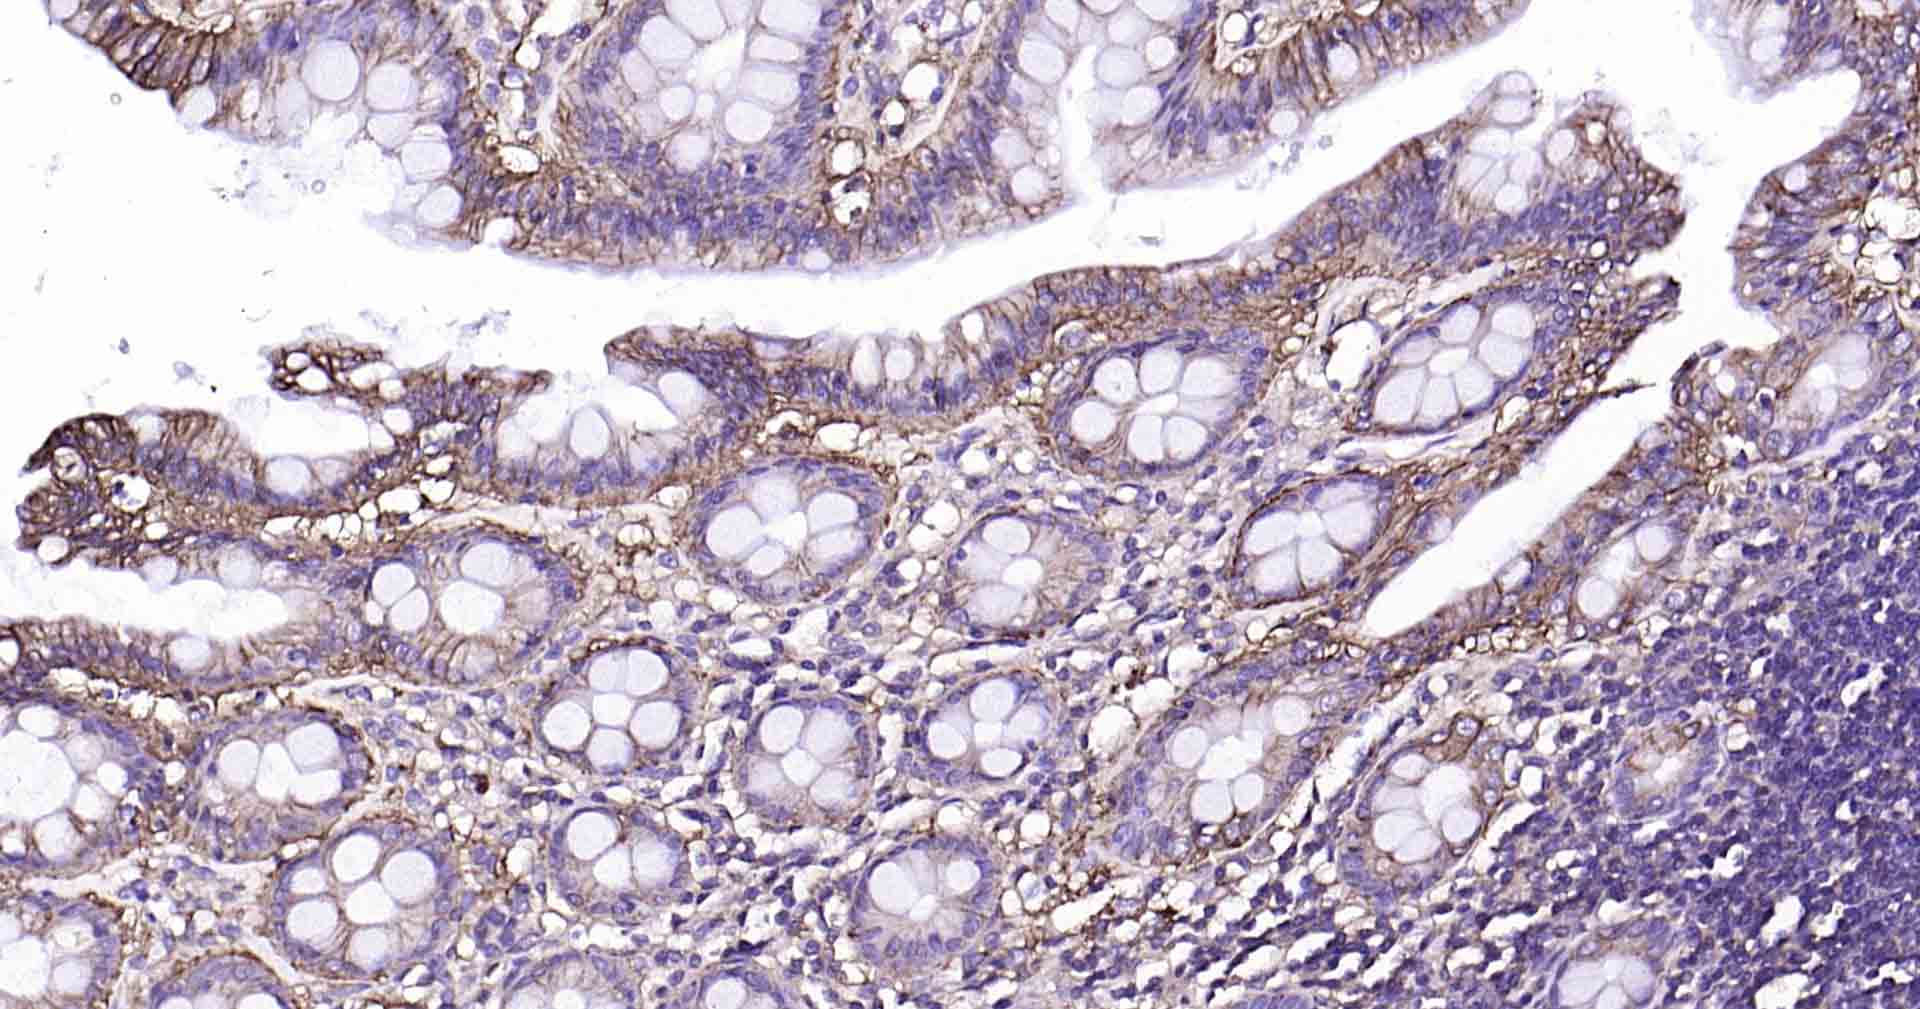
钠钾ATP酶蛋白a1单克隆抗体-bsm-34014M

Sodium Potassium ATPase Mouse mAb (一抗) - WB,IHC-P,IHC-F,IF | Bioss

货号:bsm-34014M
产品详情
相关标记
相关产品
相关文献
常见问题
概述
产品编号
bsm-34014M
产品类型
质膜蛋白内参抗体、mIHC精品抗体
英文名称
Sodium Potassium ATPase Mouse mAb
中文名称
钠钾ATP酶蛋白a1单克隆抗体
英文别名
CMT2DD; HOMGSMR2; Atpa-1; Nkaa1b; AT1A1_HUMAN; ATP1A1; Na(+)/K(+) ATPase alpha-1 subunit; Sodium pump subunit alpha-1; 7.2.2.13; AT1A1_MOUSE; AT1A1_RAT; ATPase Na+/K+ transporting subunit alpha 1; ATPase, Na+/K+ transporting, alpha 1 polypeptide; sodium/potassium-transporting ATPase subunit alpha-1; sodium-potassium ATPase catalytic subunit alpha-1
抗体来源
Mouse
免疫原
Recombinant human Sodium Potassium ATPase: 551-850/1023
亚型
IgG1, k
性状
Liquid
纯化方法
affinity purified by Protein A
克隆类型
Monoclonal
克隆号
2G11
理论分子量
113 kDa
检测分子量
110 kDa
浓度
1mg/ml
储存液
0.01M TBS(pH7.4) with 1% BSA, 0.02% Proclin300 and 50% Glycerol.
SWISS
Gene ID
保存条件
Shipped at 4℃. Store at -20 °C for one year. Avoid repeated freeze/thaw cycles.
注意事项
This product as supplied is intended for research use only, not for use in human, therapeutic or diagnostic applications.
数据库链接
产品介绍
通道蛋白(Channel Protein)
钠钾ATP酶是位于细胞膜上的一种糖蛋白,与ATP 的分解和细胞内外钠、钾离子的转运密切相关,哺乳动物各种组织细胞的钠钾ATP 酶的免疫学特性基本相同。
背景资料
The protein encoded by this gene belongs to the family of P-type cation transport ATPases, and to the subfamily of Na+/K+-ATPases. Na+/K+ -ATPase is an integral membrane protein responsible for establishing and maintaining the electrochemical gradients of Na and K ions across the plasma membrane. These gradients are essential for osmoregulation, for sodium-coupled transport of a variety of organic and inorganic molecules, and for electrical excitability of nerve and muscle. This enzyme is composed of two subunits, a large catalytic subunit (alpha) and a smaller glycoprotein subunit (beta). The catalytic subunit of Na+/K+ -ATPase is encoded by multiple genes. This gene encodes an alpha 1 subunit. Multiple transcript variants encoding different isoforms have been found for this gene. [provided by RefSeq, May2009].

产品应用
| 应用 | 已检合格种属 | 预测种属 | 推荐稀释比例 |
|---|---|---|---|
| WB | Mouse | Human, Rat | 1:2000-10000 |
| IHC-P | Human, Mouse, Rat | 1:100-500 | |
| IHC-F | Human, Mouse, Rat | 1:100-500 | |
| IF | Human, Mouse, Rat | 1:100-500 |
交叉反应
交叉反应: Human, Mouse, Rat
相关产品
暂无相关产品
靶标
基因名
ATP1A1
蛋白名
Sodium/potassium-transporting ATPase subunit alpha-1
亚基
nteracts with SIK1. Composed of three subunits: alpha (catalytic), beta and gamma. Binds the HLA class II histocompatibility antigen, DR1.
亚细胞定位
Cell membrane; Multi-pass membrane protein. Melanosome.
组织特异性
Found in most tissues.
翻译后修饰
Phosphorylation on Tyr-10 modulates pumping activity. Dephosphorylation by protein phosphatase 2A (PP2A) following increases in intracellular sodium, leading to increase catalytic activity.
相似性
Belongs to the cation transport ATPase (P-type) (TC 3.A.3) family. Type IIC subfamily.
功能
This is the non-catalytic component of the active enzyme, which catalyzes the hydrolysis of ATP coupled with the exchange of Na(+) and K(+) ions across the plasma membrane. The beta subunit regulates, through assembly of alpha/beta heterodimers, the number of sodium pumps transported to the plasma membrane.
同靶标产品
相关文献
提示: 发表研究结果有使用 bsm-34014M 时请让我们知道,以便我们可以引用参考文章。作为回馈,资料提供者将获得我们送上的小礼品。
具体参考文献:bsm-34014M 被引用于1文献中